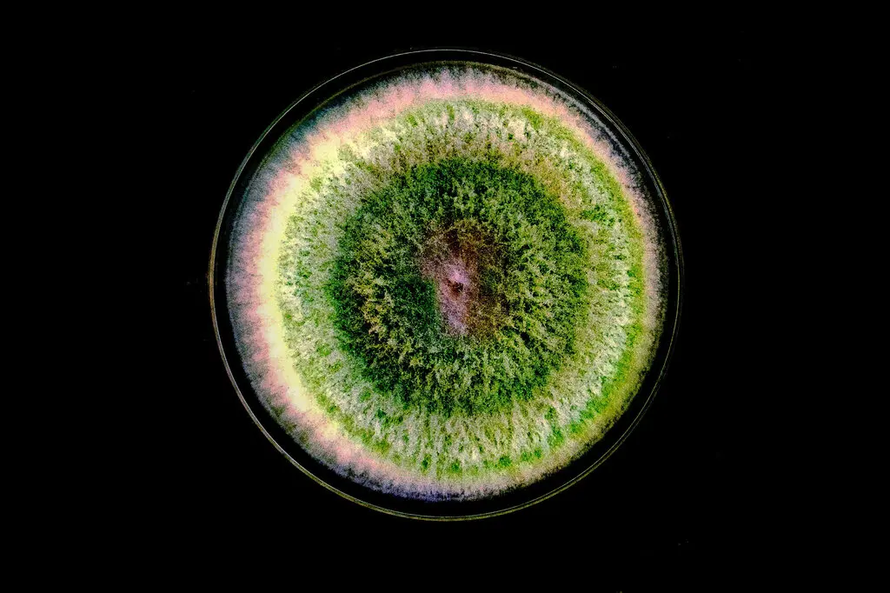
Phát âm thanh cho Trichoderma harzianum, một loại nấm xanh cực nhỏ. Ảnh: Saurabh Viahwakarma/Shutterstock

Tạp chí Biology Letters cho biết: "Đất là nơi sinh sống của nấm, vi khuẩn, bọ và giun. Nó có thể không phải là môi trường lý tưởng nhất nhưng nếu bạn sử dụng một thiết bị thu âm để ghi lại âm thanh trong đất, bạn sẽ ngạc nhiên về mức độ sôi động của nó. Điều này đã khiến một số nhà vi sinh vật học tự hỏi: Liệu có âm thanh nào thực sự khiến vi sinh vật phát triển? Và việc kích thích nấm bằng âm thanh có thể thúc đẩy sự phát triển không?"
Việc phát âm thanh cho Trichoderma harzianum, một loại nấm vi sinh vật màu xanh có khả năng bảo vệ rễ cây khỏi các tác nhân gây bệnh, đã dẫn đến tốc độ phát triển nhanh gấp 7 lần so với nấm được nuôi trong môi trường im lặng. Nếu các phát hiện trong phòng thí nghiệm có thể được xác nhận trong điều kiện tự nhiên, âm thanh có thể trở thành một công cụ mới để cải thiện sức khỏe của các hệ sinh thái rừng, khuyến khích các vi sinh vật có lợi bén rễ và phát triển mạnh.
Trong những năm gần đây, các nhà khoa học đã đặt micro trong nhiều loại môi trường khác nhau, bao gồm rừng nhiệt đới và rạn san hô. Trong quá trình này, họ đã phát hiện ra âm thanh của môi trường có thể liên quan đến sự đa dạng sinh học của môi trường đó, âm thanh càng phức tạp, các loài sinh vật càng đa dạng và khỏe mạnh. Nghiên cứu cũng cho thấy âm thanh có thể phục hồi những hệ sinh thái bị hư hại. Ví dụ, ngoài khơi Adelaide-Úc, các nhà khoa học đã phát hiện âm thanh ghi lại của các rạn hàu khỏe mạnh có thể thu hút ấu trùng hàu mới đến những khu vực bị tàn phá do đánh bắt quá mức.
"Âm thanh dường như cũng giúp một số loại vi khuẩn phát triển", Tiến sĩ Jake Robinson, nhà sinh thái học vi sinh tại Đại học Flinders (Úc), người nghiên cứu về hệ vi sinh vật trong đất cho biết. Công việc nghiên cứu này đã truyền cảm hứng cho Tiến sĩ Robinson và các đồng nghiệp của ông thử nghiệm với nấm.
Đầu tiên, các nhà khoa học đã lót đáy những chiếc thùng nhựa lớn bằng bọt cách âm để tạo ra nơi yên tĩnh cho nấm phát triển. Sau đó, họ đặt các đĩa petri chứa một chút T. harzianum vào trong các thùng này. Mỗi ngày một lần, họ phát âm thanh trắng trong 30 phút, được lấy từ một video trên YouTube dành cho những người bị ù tai. Đồng thời, họ đánh giá số lượng bào tử nấm tạo ra và lượng tế bào bao phủ đĩa.
Ban đầu, những đĩa không được tiếp xúc với âm thanh trắng và những đĩa có tiếp xúc trông gần giống nhau. Ngày thứ 3 của thí nghiệm, những loại nấm được tiếp xúc với âm thanh đã bắt đầu phát triển mạnh mẽ. Bào tử của T. harzianum chuyển sang màu xanh lá, các đĩa âm thanh trắng nhanh chóng chuyển sang màu xanh rêu. Đến ngày thứ 5, các nhà nghiên cứu đã có thể tính toán rằng việc tiếp xúc với âm thanh đã khiến nấm phát triển nhanh gấp 7 lần và tạo ra nhiều bào tử hơn gấp 4 lần.
Hiện vẫn chưa rõ tại sao âm thanh lại có những tác động này. Tiến sĩ Robinson suy đoán rằng sóng âm có thể tác động lên các thụ thể trong tế bào nấm nhạy cảm với áp suất. Những thụ thể này có thể dẫn đến một chuỗi tín hiệu kích hoạt gen tăng trưởng. Các nhà nghiên cứu dự định sẽ xem xét kỹ lưỡng các gen hoạt động và không hoạt động khi có âm thanh để hiểu rõ hơn về các tác động này.